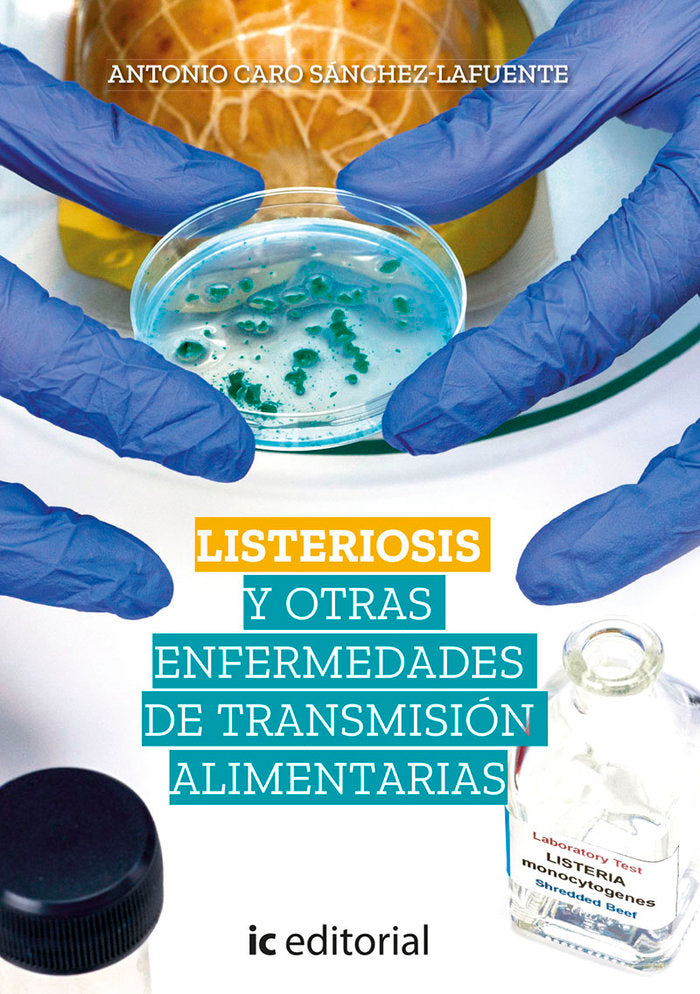
LISTERIOSIS Y OTRAS ENFERMEDADES DE TRANSMISION ALIMENTARIAS - 9788491989684

LISTERIOSIS Y OTRAS ENFERMEDADES DE TRANSMISION ALIMENTARIAS - 9788491989684
Recíbelo entre el 29/06 y el 30/06 · Pedidos antes de las 12:00h
ENVÍO RÁPIDO Y SEGURO
Envíos Gratis a partir de 80€ de Compra (3,99€ Coste de Envío habitual) - Envíos Express en 24-48 horas en Pedidos realizados antes de las 12:00 pm
COMPRA INTELIGENTE
Utiliza el - CHAT EN VIVO - para asegurar Stock y Tiempos de Envío Estimado con Nuestro Equipo de forma Directa. Esta es la mejor forma de utilizar nuestra plataforma y Obtener el mejor Servicio Posible.
DEVOLUCIONES GRATIS 14 DÍAS
Tienes 14 días para devolverlo con total tranquilidad. Si el producto llega dañado o incorrecto, lo solucionamos gratis. Si simplemente cambias de opinión, solo se descontarán los gastos de envío del reembolso. Sin líos y sin preguntas incómodas.
¿Dudas? Escríbenos por el Chat en Vivo
Te respondemos en segundos. Stock, envíos, recomendaciones — como preguntar a tu dependiente de confianza, pero sin moverte de casa.
Atención, fans de Warhammer:
Compra en PREPEDIDO y consigue tus miniaturas con descuento. Funciona como pedir directamente a Games Workshop, pero a mejor precio. Haces el pedido, lo recibimos en 7-10 días y te lo enviamos.
Planifica tus compras y ahorra en cada caja.
¿Te interesa? Escríbenos por el chat y lo gestionamos contigo.
¿Dudas sobre disponibilidad?
Trabajamos con almacenes conectados en tiempo real. Si quieres confirmación al 100%, escríbenos por el chat en vivo y te lo verificamos al instante.
Plazos de envío
| Desde tienda | Sobre catálogo | |
|---|---|---|
| Warhammer / GW | 24‑48h | 7‑12 días |
| Libros y cómics | 24‑48h | — |
| Libros de texto | 24‑48h | 7‑10 días |
| Papelería y regalos | 24‑48h | — |
Envío gratis a partir de 80€. Si un producto no está disponible, te reembolsamos de inmediato.
Devoluciones — 14 días
Devuelve cualquier producto en su estado original dentro de los 14 días. Te enviamos etiqueta de devolución lista para imprimir.
- Producto dañado o incorrecto: lo cambiamos o reembolsamos sin coste alguno.
- Devolución por otros motivos: se descontarán los gastos de envío del reembolso.
¿Necesitas ayuda? Escríbenos por el chat en vivo.
PRODUCTOS VISTOS RECIENTEMENTE
PRODUCTOS RELACIONADOS